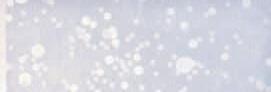

JANUARY
Finduson P ub lishedonthelastSaturday ofevery mo nthby TheBerk sh ireEa gle .
LENOX – Welcometoyourspaciousmid-centuryhomenear downtownLenox.Sittingon2.4acres,thisexpansivehousehas over3,000sqftfeaturingmany amenities.Threeadditionalbuildings includea20x40studio,a20x60detachedgaragewith workshop,shed.Largegalleykitchen,greatroom/ replace/skylights,4bdrms/4ba,homeo ce,wraparoundporch/screened porch,in-lawguestsuite(bdrm/ba,kitchenette).Widerangeoffabulousfruit vegetationontheproperty. $769,900 R3144
LEN OX -CharmingNewEnglandfarmhousewithinviting frontporch!Datingfrom1870,loadedwithcharm,butlots oftoday’screaturecomfortsandconveniences!Hardwood oors, rst oorlaundry,fullbath.Second oor-suite dressingroomandfullbath.Twoadd’lbdrms/fullbath.New reardeck.Walktotownandshops. $399,0 00/R3135
Happy Holidays
PITTSFI EL D -DesirableSoutheastRanch!Enjoyone oor livingwiththis3bedroom2bathroomhome.2 replaces. Masterbedroomwithonsuite.2ndbathroomhasbeen recentlyupdated.DeckwithawningwithaccessfromMaster BedroomandDiningRoom.Lotsofstoragearea.Basementis partial nishedwitha4thbedroompossible. $399,0 00/R3137
NEWC ON STRUCTION AT BERKS HI RECOUNTRY ME ADOWS
Select nishestoyourownpersonaltaste.Contemporaryone-levelopenlivingplan.Hardwood oors,gas replace,2-3bedrooms,generouslysizedprimarysuite,Screenedporch,attachedtwo-cargarage,naturalgas,centrala/c. Pool/tennis/clubhouseonsite.Readyfor2024! $759,000.C3050
GT.BARRIN GT ON -Well-maintainedcolonialnearbeautifulhikingtrailsandconvenienttotown!Invitingopen oor plan.Naturallight- lledlivingroomw/gas replace.Spacious kitchen/diningareawithhardwood rs,loadsofcabinetryand counterspaces.Familyroomandahalfbathw/laundry.Three guestbdrms/fullbath.Mainbedroomsuitewithwalk-incloset andspaciousbath.Finished,walkoutlowerlevel.Twocargarage,reardeck.Naturalgas. $6 49,0 00 R3145
BECKET -Don’tmissthiswonderfulraisedranchon5.8 acres!Enjoycountrysideviewsandprivatelakeaccessthrough TheCenterLakeEstatesacrossthestreet.Largeeat-inkitchen andlivingroomwithaccesstothebackdeck,3bedrooms,and apartially nishedbasementwithlotsofpotential.Closeto alloftheculturalcharmsoftheBerkshires. $339,000/R3128
LAKEC OM MUNITYOPTIONS
LAKECREST-THREEUNITSTOCHOOSEFROM-$529,000-$589,000 – GatedcondocommunityonPontoosuc Lake!Threebedroomendunitwithonelevelliving,withgreatroom,kitchen, rst oorprimarysuiteandlaundry.Second levelincludesspaciousloftarea,twoadditionalbedroomsandafullbath.Greatroomincludesa replaceandsliderstoan extralargesideandreardeck!Attachedgarage,naturalgasheatandcentralair.Thiswell-establishedcommunityincludes clubhouse, tnesscenter,heatedpool,3tenniscourts(one ttedforpickleball)alongwithkayak/canoestorageanddocksfor thelargerboats.$529,000/C3131




















RICHMOND -Muchmorethanapieceofland,thisestateparcelconveys withmanypermitsin placetostreamlineyourbuildingprocess.Unique mountain-topretreatonovereightprivateacresborderingalargetract(14 acres)oftown-ownedconservationland.Beautifulviewsovermountains andmeadows.Hikeandexploreyourownforestwithmaturetreesand year-roundbrook.Permitsforseptic,well,scenicmountainandconservationworkinhand.Drivewaytothetopoftheparcelisin!Twomiles/ ve minutestoTanglewoodand/orKripalu. $585,000/L2733
LENOXCONDOS
BIRCHWOODVILLAGE – LENOX -LovelycondosituatedacrossfromtheMiravalResort.A feelofprivacywithareardeckfacingwoodedconservationland.Customkitchenandbathcabinets. Newstainlesssteelappliances.Newfurnace,waterheateranda/cunit.Tenniscourtandpoolasa perfectretreatforyourentirefamilytocomeandenjoytheBerkshires.MinutestoTanglewoodand theLeeOutlets.$637,000/C3148
DALTON -Beautifulparceloflandon3+acres.Conveniently located,completelycleared,level,openparcelborderedbywoods forprivacy.Accesstopublic sewerandpublic watersourceatthe entrancetothe lot.Gorgeousmountainviewsduringeveryseason-readyforbuildingyournewhome. $149,900/L3113
Broker/Owners:
LEE-Almost190acresofpanoramicviewsboastthisspectacular,one-of-akind,undevelopedpropertylocatedintheheartoftheBerkshiresinWestern Massachusetts.Convenientlylocatedo I-90,amainarterybetweenBoston andNewYork,thispropertyhasunlimitedpotential forthoseseekingavibrant culturalareanestledinallthingsnatural.Fromatranquilbrooktoamplelocationsforprivacyandviewsfromeachpotentialbuildingpoint,theapexofthis propertyo ersbreathtakingvistasthatgoonformilesandmiles.Openareas oflandanddensewoodedspotsgivethispropertyadiverserangeofoptionsfor developers.LocatedwithinminutesofTanglewoodand,forthoseitchingforthe outdoors,GoosePondandtheAppalachianTrailarenearby. $1,495,000/L3003
PamRoberts, CBR,CIPS, CRB,CRS,ePro,GRI,SRES441-9681
Ti anyRoberts, ABR,CBR,e-PRO822-5369
MarieBourassa,PSA,SES,SRES212-6174
Lenox - MakethisLenoxculde-sacneighborhoodthesiteof yournewhome!Undergroundutilities,naturalgas,townwater &sewer.1.8acreclosetoLenoxcenterandtheLenoxMiddle andHighSchool.Minutes fromculturalattractionsandoutdoor recreation! $209,000 L2970
ROLLINGHILLS – LENOX – TurnkeycondoopportunityinLenox!Condoconveniencewith on-siteamenities. Light- lledendunit withprivatereardeck/awning,twobedroomswithprivate bath.Openkitchenwithextendedcounterforservingordining.Finished lowerlevelwithfamily room/laundry/bathwithshower.Gasheat,centrala/c.Pool,hottub,clubhouse,kayakstorage, walkingtrails,dogrunarea. $314,900/C3134
INVESTORS/DEVELO PE RSTAKENOTE!
S AVOY -Escapeon130+acresonacountryRoad.Over 2,000ftoffrontagewithacreageonbothsidesofthestreet. The1870soldhomesteadhasbeenusedforsummerseasons only(noheatingsystem).100+acresofrecentlytimberedand woodedacreageonthe‘’leftside’’whilethe‘’rightside’’is another30+acresofopenmanicured,levellawnsandpaths abuttingstateforest!Firsttimeo ered. $495,000/R3055
WelcometoWoodmont! SitedinWestPitts eld,thisgated communityhassomechoicelotslefttobuildyourdream home.LowHOAfees,communitytenniscourt.underground utilities.Drilledwellisdone.Spectacularlocationattheend ofOldFarmLanecul-de-sac. $45,50 0 L3121
BrokerAssociates:
BarbaraK.Greenfeld, ABR,C-CREC,CRS,Green,RSPS,SRES441-5986
AnneMeczywor,CBR,CRS,MRP,RSPS,SRES446-2179
RealtorAssociates:
NicholasSereda,SRES,441-0694
BonnieParsons, GREEN® 617-719-4387
MollyThomas 441-3899
BrianWright 822-3830
MarkParsons 822-4169
JENHARVEYCO-FOUNDER
TOMLYNCH
DEBORAHLEVINSON MONTELEVIN
BARBARASCHULMAN
CLAUDIACRANE
GARYLAZARUS
FINHANLEY
SELINALAMB
CHRISTINEMARTIN
JONATHANHANKIN
RACHELLOUCHEN
RUSSSTEIN ROBINBAN
KATELASCAR
SUSANLAIDLAW
"We askedthecompan yto do a major expansion of our screenedporchsothat it mor e thandoubledinsize and functionedas a three-season r oom.Thefinalproduct c ame out ev enbe tt erthan we ha d anticip at ed.
Ourthanksto St eve Morrison and ev eryonein v olvedin bringingthisproject to completion.Thisthreeseason r oomwillgiv e our familyman yyear sof pleasur e andhas a dded value to our home."
ANDY LIPP S ANDEVA SEREGHY
Seecomple tetestimonialand a dditionalpho tosof thisproject at w ww.mo r risonshomeimp rovement.co m
•24”clearingwidth •62tons/hour •254ccAriensAX® engine
Startingat$1,449 DELUXE24SNOWBLOWER #921045
Othermodelsstartat$1,349
DaltonPineCrestEstates 8room,4bedroom,2.5bath homewithfirstfloormaster bedroomsuite,openfloorplan, cathedralceilinggreatroomwith fireplace,formaldiningroom, kitchenwithbreakfastnook,first floorlaundry,twocargarage.
tsfield 1bedroom1Bathcondoupdates includenewskylight4yearsold, newwaterheater2yearsold,tile andwoodflooring,updatedbath, gashotwaterandheat,$201.11 amonthHOAincludessewer, water,masterinsurance,$149,900
Pit tsfield Singlefamilyranch2Bedrooms,1 Bath,vinylsidingandreplacement windows, recently painted throughout,newkitchen flooring, nobasement,streetnothrough traffic$209,000 CallCharlesat413-358-5524
LOTSFORSALE
DaltonPineCrestEstates Thisrefinedfamilyhomeconsistsof 4bedrooms,amasterbedroomsuite withmasterbath,alongwithtwofamily baths.Thegreatroomfeaturesavaulted ceilingandafireplace.Cathedralceiling enhancesthediningroom,plusithasa breakfastnook,anda2cargarage. CallCharlesat413-358-5524
Pit tsfield 4bedroom,2fullbaths, remodeledt hroug hou t. Centrallyloc ated. CallCharlesat413-358-5524
•Inbusinesssince1984,Familyownedandoperated
•Superiorworkmanship,fullylicensed&insured
•Highestenergye iciency,Allwindowsenergy starratedorbetter
•Manyinteriorandexteriorcolor&woodgrainoptions
•100%lifetimewindowwarranty,fullytransferable
•Simple&easyfinancing
•Interestfreeplusnopaymentsforupto6months
You’veGotQuestions?
Q
byLynnArseneau
HiLynn, Justfinishedmaking your Lef toverTurkeyBur ritos.Theywere delicious!Wetoppedthemwithhotsauce fromTucson.Justfantastic!
Please postanygreatChristmasrecipes youhave.We’dlovetotrythem. Wishing youandyourfamilyawonderful Christmassea son.
Best,Tracy&Jeff
AHiTracyandJeff, WOW!TH AT ’SGRE AT TH AT YOUMADETHERECIPETHAT WASINDEARLYNN!HERE’SANEW YEAR’SEVE(ORDAY)FROM“ALL RECIPES.”
GreatestStuffedMushroomsEver
•12wholefreshmushrooms
•1tablespoonvegetableoil
•1tablespoonminced garlic
•1(8ounce)packagecreamcheese, sof tened
• ¼ cupgratedParmesancheese
• ¼ teaspoongroundblackpepper
• ¼ teaspoononion powder
• ¼ teaspoongroundcayennepepper Preheattheovento350degreesF.Spray abaking sheetwithcooking spray.Clean mushroomswithadamppapertowel;
Hopingthatthisyearwillbringyouamortgage,realestatetaxes,and homeowners’insurance.It’sthesmartestinvestmentyou’llevermake!
I’vebeenaRealtorfor36years.Peoplefrequentlyaskfor myadviceandopinions,andbysharingthosequestionsand answerswithyou,Ihopetoo ersomehelpfulinformation
carefullybreakoffstems.Chopstems extremelyfine,discarding thetoughend of stems.
•Heatoilinalargeskilletovermedium heat.Add garlicandchoppedmushroom stems;fryuntilanymoisturehas evaporated,taking carenottoburn garlic. Setasidetocool.
•Stirincreamcheese,Parmesancheese, blackpepper,onion powder,andcayenne. Themixturewillbeverythick;usea teaspoontofilleachmushroomcapwith agenerousamountofstuffing.Arrange mushroomcapsonthepreparedcookie sheet.
•Bakeinthepreheatedovenuntil themushroomsarepiping hot,about20 minutes.
HiLynn, Ireallyenjoyyourcolumnand nowIhaveaquestionforyou: We’rehaving ourbathroomremodeled thisspring.Nooneinourfamilytakes bathsandI’dlovetohaveabeaut if ulwalkinshowerinsteadofatub.Thereisonly onebathroom.Wouldlackofabathtub effecttheresalepriceofthehouse?
Joan
AHi Joan, I’msopleasedthatyoulike DearLynn,thankyouverymuch! Regarding thetubvsshower.Whena homehasonebathonly,it’sbettertohave atubandshowercombo.Peoplewith smallchildrencommonlypreferhaving bathtubsforthoselittleones.Trending noware“soaking”tubs,largeenoughto sinkdownlowandstretchout!Sounds great,doe sn’tit?
Here’swhatI’mthinking:Doyouhave enoughspacetoputinatubandashower stal l? Ifso,thatmaybeyoursolution. So,here’smypersonalthought.We alldo improvementsandremodeling inourhomesforourenjoyment.Ifyou wouldreallyenjoyalargewalk-inshower, maybethattakesprecedenceoverbeing concernedaboutresale.Whoknows? Whenyouselltheremaybeabuyerthat wouldloveitthatway.Anotherthi ng to thinkaboutishowlong youplantolive inyourhome.Iftheansweristhatyou don’tseeamovesoonerthanlateryoumay wanttobuildwhatyou’redreaming of.
Life’sshort, if ashowerwillbeenjoyed andbesafer,youmayjustgoforit!